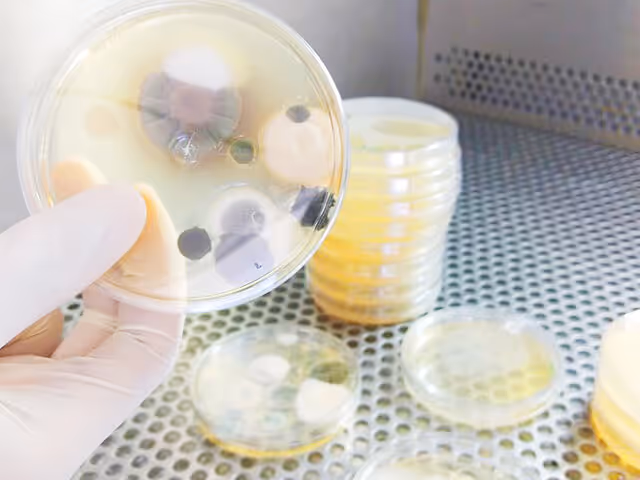

Qualidade do Ar
Artigos sobre qualidade do ar interior, PMOC, ventilação e climatização
Filtrar por Categoria

LBN Análises
Nov 22, 2016
Qualidade do Ar
Eco-Cooler: Faça Seu Próprio Ar-Condicionado com Materiais Recicláveis
Aprenda a fazer um resfriador sustentável com materiais recicláveis sem custo na sua conta de luz

LBN Análises
Nov 3, 2016
Qualidade do Ar
Análise Microbiológica do Ar em Ambientes Climatizados
A análise microbiológica deve ser realizada semestralmente em ambientes públicos e coletivos climatizados para atender à RE 09 da ANVISA

LBN Análises
Sep 14, 2016
Qualidade do Ar
Padrões de Qualidade do Ar e a RE 09 da ANVISA
Conheça os padrões de qualidade do ar em ambientes climatizados e como a análise atende à Resolução RE 09

LBN Análises
Aug 26, 2016
Qualidade do Ar
Ambiente Climatizado | Bem-Estar e Conforto ao Seu Alcance
O ar‑condicionado proporciona bem‑estar e conforto, mas é preciso atenção à temperatura ideal e a outros cuidados importantes
LBN Análises
Jul 28, 2016
Qualidade do Ar
Análise da Qualidade do Ar em Ambientes Climatizados
A análise avalia parâmetros de conforto, detecta níveis de dióxido de carbono e identifica fungos patogênicos em ambientes internos